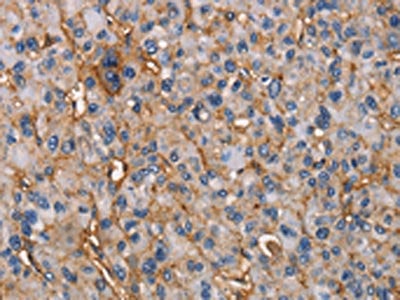
product-image-AAA238388_IHC13.jpg

5'-nucleotidase (NT5E) Recombinant Protein | NT5E recombinant protein
Recombinant Human 5'-nucleotidase (NT5E), partial
Gene Names
NT5E; NT; eN; NT5; NTE; eNT; CD73; E5NT; CALJA
Purity
Greater or equal to 85% purity as determined by SDS-PAGE.
Synonyms
5'-nucleotidase (NT5E); N/A; Recombinant Human 5'-nucleotidase (NT5E), partial; Ecto-5'-nucleotidase; CD73; NT5E recombinant protein
Host
E Coli or Yeast or Baculovirus or Mammalian Cell
Purity/Purification
Greater or equal to 85% purity as determined by SDS-PAGE.
Form/Format
Lyophilized or liquid (Format to be determined during the manufacturing process)
Sequence Positions
28-547aa; Partial
Sequence
ELTILHTNDVHSRLEQTSEDSSKCVNASRCMGGVARLFTKVQQIRRAEPNVLLLDAGDQYQGTIWFTVYKGAEVAHFMNALRYDAMALGNHEFDNGVEGLIEPLLKEAKFPILSANIKAKGPLASQISGLYLPYKVLPVGDEVVGIVGYTSKETPFLSNPGTNLVFEDEITALQPEVDKLKTLNVNKIIALGHSGFEMDKLIAQKVRGVDVVVGGHSNTFLYTGNPPSKEVPAGKYPFIVTSDDGRKVPVVQAYAFGKYLGYLKIEFDERGNVISSHGNPILLNSSIPEDPSIKADINKWRIKLDNYSTQELGKTIVYLDGSSQSCRFRECNMGNLICDAMINNNLRHTDEMFWNHVSMCILNGGGIRSPIDERNNGTITWENLAAVLPFGGTFDLVQLKGSTLKKAFEHSVHRYGQSTGEFLQVGGIHVVYDLSRKPGDRVVKLDVLCTKCRVPSYDPLKMDEVYKVILPNFLANGGDGFQMIKDELLRHDSGDQDINVVSTYISKMKVIYPAVEGRIK
Preparation and Storage
Store at -20 degrees C. For long-term storage, store at -20 degrees C or -80 degrees C. Store working aliquots at 4 degrees C for up to one week. Repeated freezing and thawing is not recommended.
Related Product Information for NT5E recombinant protein
Hydrolyzes extracellular nucleotides into membrane permeable nucleosides. Exhibits AMP-, NAD-, and NMN-nucleosidase activities.
Product Categories/Family for NT5E recombinant protein
References
Primary structure of human placental 5'-nucleotidase and identification of the glycolipid anchor in the mature form.Misumi Y., Ogata S., Ohkubo K., Hirose S., Ikehara Y.Eur. J. Biochem. 191:563-569(1990) Signal sequence and keyword trap in silico for selection of full-length human cDNAs encoding secretion or membrane proteins from oligo-capped cDNA libraries.Otsuki T., Ota T., Nishikawa T., Hayashi K., Suzuki Y., Yamamoto J., Wakamatsu A., Kimura K., Sakamoto K., Hatano N., Kawai Y., Ishii S., Saito K., Kojima S., Sugiyama T., Ono T., Okano K., Yoshikawa Y., Aotsuka S., Sasaki N., Hattori A., Okumura K., Nagai K., Sugano S., Isogai T.DNA Res. 12:117-126(2005) The DNA sequence and analysis of human chromosome 6.Mungall A.J., Palmer S.A., Sims S.K., Edwards C.A., Ashurst J.L., Wilming L., Jones M.C., Horton R., Hunt S.E., Scott C.E., Gilbert J.G.R., Clamp M.E., Bethel G., Milne S., Ainscough R., Almeida J.P., Ambrose K.D., Andrews T.D., Ashwell R.I.S., Babbage A.K., Bagguley C.L., Bailey J., Banerjee R., Barker D.J., Barlow K.F., Bates K., Beare D.M., Beasley H., Beasley O., Bird C.P., Blakey S.E., Bray-Allen S., Brook J., Brown A.J., Brown J.Y., Burford D.C., Burrill W., Burton J., Carder C., Carter N.P., Chapman J.C., Clark S.Y., Clark G., Clee C.M., Clegg S., Cobley V., Collier R.E., Collins J.E., Colman L.K., Corby N.R., Coville G.J., Culley K.M., Dhami P., Davies J., Dunn M., Earthrowl M.E., Ellington A.E., Evans K.A., Faulkner L., Francis M.D., Frankish A., Frankland J., French L., Garner P., Garnett J., Ghori M.J., Gilby L.M., Gillson C.J., Glithero R.J., Grafham D.V., Grant M., Gribble S., Griffiths C., Griffiths M.N.D., Hall R., Halls K.S., Hammond S., Harley J.L., Hart E.A., Heath P.D., Heathcott R., Holmes S.J., Howden P.J., Howe K.L., Howell G.R., Huckle E., Humphray S.J., Humphries M.D., Hunt A.R., Johnson C.M., Joy A.A., Kay M., Keenan S.J., Kimberley A.M., King A., Laird G.K., Langford C., Lawlor S., Leongamornlert D.A., Leversha M., Lloyd C.R., Lloyd D.M., Loveland J.E., Lovell J., Martin S., Mashreghi-Mohammadi M., Maslen G.L., Matthews L., McCann O.T., McLaren S.J., McLay K., McMurray A., Moore M.J.F., Mullikin J.C., Niblett D., Nickerson T., Novik K.L., Oliver K., Overton-Larty E.K., Parker A., Patel R., Pearce A.V., Peck A.I., Phillimore B.J.C.T., Phillips S., Plumb R.W., Porter K.M., Ramsey Y., Ranby S.A., Rice C.M., Ross M.T., Searle S.M., Sehra H.K., Sheridan E., Skuce C.D., Smith S., Smith M., Spraggon L., Squares S.L., Steward C.A., Sycamore N., Tamlyn-Hall G., Tester J., Theaker A.J., Thomas D.W., Thorpe A., Tracey A., Tromans A., Tubby B., Wall M., Wallis J.M., West A.P., White S.S., Whitehead S.L., Whittaker H., Wild A., Willey D.J., Wilmer T.E., Wood J.M., Wray P.W., Wyatt J.C., Young L., Younger R.M., Bentley D.R., Coulson A., Durbin R.M., Hubbard T., Sulston J.E., Dunham I., Rogers J., Beck S.Nature 425:805-811(2003) Isolation and characterization of the promoter of the human 5'-nucleotidase (CD73) -encoding gene.Hansen K.R., Resta R., Webb C.F., Thompson L.F.Gene 167:307-312(1995) Zanoni L., Rosi F., Pagani R., Marinello E. Characterization of soluble vs membrane-bound human placental 5'-nucleotidase.Klemens M.R., Sherman W.R., Holmberg N.J., Ruedi J.M., Low M.G., Thompson L.F.Biochem. Biophys. Res. Commun. 172:1371-1377(1990) Glycoproteomics analysis of human liver tissue by combination of multiple enzyme digestion and hydrazide chemistry.Chen R., Jiang X., Sun D., Han G., Wang F., Ye M., Wang L., Zou H.J. Proteome Res. 8:651-661(2009) Mass-spectrometric identification and relative quantification of N-linked cell surface glycoproteins.Wollscheid B., Bausch-Fluck D., Henderson C., O'Brien R., Bibel M., Schiess R., Aebersold R., Watts J.D.Nat. Biotechnol. 27:378-386(2009) The high-resolution crystal structure of periplasmic Haemophilus influenzae NAD nucleotidase reveals a novel enzymatic function of human CD73 related to NAD metabolism.Garavaglia S., Bruzzone S., Cassani C., Canella L., Allegrone G., Sturla L., Mannino E., Millo E., De Flora A., Rizzi M.Biochem. J. 441:131-141(2012) An enzyme assisted RP-RPLC approach for in-depth analysis of human liver phosphoproteome.Bian Y., Song C., Cheng K., Dong M., Wang F., Huang J., Sun D., Wang L., Ye M., Zou H.J. Proteomics 96:253-262(2014) Crystal structure of the human ecto-5'-nucleotidase (CD73) insights into the regulation of purinergic signaling.Knapp K., Zebisch M., Pippel J., El-Tayeb A., Muller C.E., Strater N.Structure 20:2161-2173(2012) NT5E mutations and arterial calcifications.St Hilaire C., Ziegler S.G., Markello T.C., Brusco A., Groden C., Gill F., Carlson-Donohoe H., Lederman R.J., Chen M.Y., Yang D., Siegenthaler M.P., Arduino C., Mancini C., Freudenthal B., Stanescu H.C., Zdebik A.A., Chaganti R.K., Nussbaum R.L., Kleta R., Gahl W.A., Boehm M.N. Engl. J. Med. 364:432-442(2011) NT5E mutations that cause human disease are associated with intracellular mistrafficking of NT5E protein.Fausther M., Lavoie E.G., Goree J.R., Baldini G., Dranoff J.A.PLoS ONE 9:E98568-E98568(2014)
NCBI and Uniprot Product Information
NCBI GI #
NCBI GeneID
NCBI Accession #
NCBI GenBank Nucleotide #
Molecular Weight
85kD
NCBI Official Full Name
5'-nucleotidase isoform 2 preproprotein
NCBI Official Synonym Full Names
5'-nucleotidase ecto
NCBI Official Symbol
NT5E
NCBI Official Synonym Symbols
NT; eN; NT5; NTE; eNT; CD73; E5NT; CALJA
NCBI Protein Information
5'-nucleotidase
UniProt Protein Name
5'-nucleotidase
UniProt Gene Name
NT5E
UniProt Synonym Gene Names
NT5; NTE; 5'-NT
UniProt Entry Name
5NTD_HUMAN
Customer Reviews
Loading reviews...
Share Your Experience
Similar Products
Product Notes
The NT5E nt5e (Catalog #AAA113569) is a Recombinant Protein produced from E Coli or Yeast or Baculovirus or Mammalian Cell and is intended for research purposes only. The product is available for immediate purchase. The immunogen sequence is 28-547aa; Partial. The amino acid sequence is listed below: ELTILHTNDV HSRLEQTSED SSKCVNASRC MGGVARLFTK VQQIRRAEPN VLLLDAGDQY QGTIWFTVYK GAEVAHFMNA LRYDAMALGN HEFDNGVEGL IEPLLKEAKF PILSANIKAK GPLASQISGL YLPYKVLPVG DEVVGIVGYT SKETPFLSNP GTNLVFEDEI TALQPEVDKL KTLNVNKIIA LGHSGFEMDK LIAQKVRGVD VVVGGHSNTF LYTGNPPSKE VPAGKYPFIV TSDDGRKVPV VQAYAFGKYL GYLKIEFDER GNVISSHGNP ILLNSSIPED PSIKADINKW RIKLDNYSTQ ELGKTIVYLD GSSQSCRFRE CNMGNLICDA MINNNLRHTD EMFWNHVSMC ILNGGGIRSP IDERNNGTIT WENLAAVLPF GGTFDLVQLK GSTLKKAFEH SVHRYGQSTG EFLQVGGIHV VYDLSRKPGD RVVKLDVLCT KCRVPSYDPL KMDEVYKVIL PNFLANGGDG FQMIKDELLR HDSGDQDINV VSTYISKMKV IYPAVEGRIK. It is sometimes possible for the material contained within the vial of "5'-nucleotidase (NT5E), Recombinant Protein" to become dispersed throughout the inside of the vial, particularly around the seal of said vial, during shipment and storage. We always suggest centrifuging these vials to consolidate all of the liquid away from the lid and to the bottom of the vial prior to opening. Please be advised that certain products may require dry ice for shipping and that, if this is the case, an additional dry ice fee may also be required.Precautions
All products in the AAA Biotech catalog are strictly for research-use only, and are absolutely not suitable for use in any sort of medical, therapeutic, prophylactic, in-vivo, or diagnostic capacity. By purchasing a product from AAA Biotech, you are explicitly certifying that said products will be properly tested and used in line with industry standard. AAA Biotech and its authorized distribution partners reserve the right to refuse to fulfill any order if we have any indication that a purchaser may be intending to use a product outside of our accepted criteria.Disclaimer
Though we do strive to guarantee the information represented in this datasheet, AAA Biotech cannot be held responsible for any oversights or imprecisions. AAA Biotech reserves the right to adjust any aspect of this datasheet at any time and without notice. It is the responsibility of the customer to inform AAA Biotech of any product performance issues observed or experienced within 30 days of receipt of said product. To see additional details on this or any of our other policies, please see our Terms & Conditions page.Item has been added to Shopping Cart
If you are ready to order, navigate to Shopping Cart and get ready to checkout.